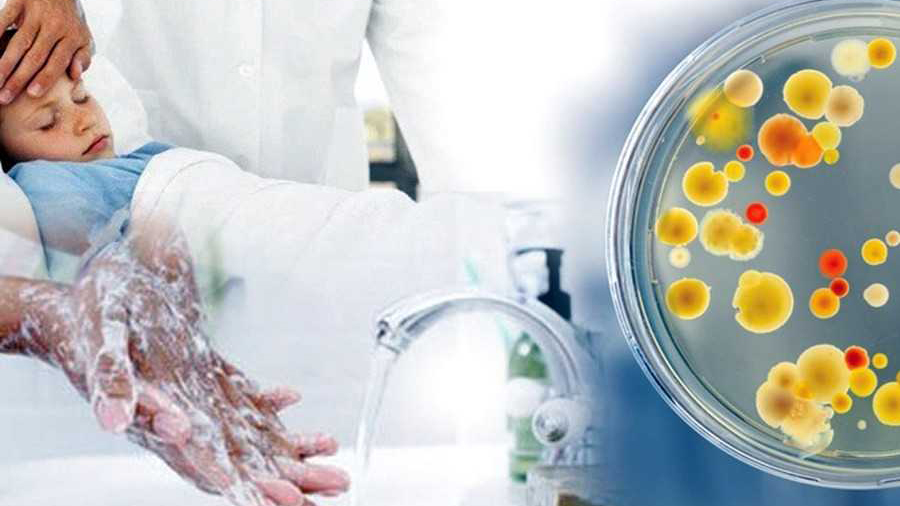
Інформує Лубенський підрозділ ДУ "«Полтавський обласний центр контролю та профілактики хвороб"

Незважаючи на всі випробування, які випали на долю українців, ми залишаємося сильними та незламними, а народження маленьких громадян нашої держави є символом надії, продовження життя, чітким усвідомлення того, що дух української нації ніколи не здолати.
За інформацією Управління охорони здоров’я виконавчого комітету Лубенської міської ради з 24.02.2022 р. по 10.06.2024 р. в пологовому відділенні КП «Лубенська лікарня інтенсивного лікування» ЛМР народилося 730 дітей: 362 дівчинки і 368 хлопчиків, в тому числі за 2024 рік народилося 116 дітей : 56 дівчаток і 60 хлопчиків.